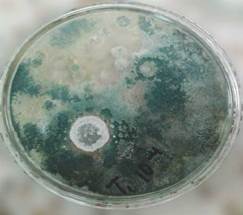

Ciencias Agrarias
Evaluación de variables agronómicas, calidad del forraje y contenido de taninos condensados de la leguminosa Lotus corniculatus en respuesta a biofertilizante y fertilización química en condiciones agroecológicas de trópico alto andino colombiano
Evaluation of agronomic variables, forage quality and content of condensed tannins of the legume Lotus corniculatus in response of biological and chemical fertilization in agro-ecological conditions of high Andean tropical Colombian
Avaliação de características agronômicas e qualidade da forragem de taninos condensados conteúdo leguminosa Lotus corniculatus de em resposta a biofertilizante e adubação química em condições ecológicas de alta Andina trópico colombiano
Evaluación de variables agronómicas, calidad del forraje y contenido de taninos condensados de la leguminosa Lotus corniculatus en respuesta a biofertilizante y fertilización química en condiciones agroecológicas de trópico alto andino colombiano
Entramado, vol. 13, núm. 1, pp. 222-233, 2017
Universidad Libre de Cali
Recepción: 21 Junio 2016
Aprobación: 25 Octubre 2016
RESUMEN: En la sabana de Bogotá, 2600 m.s.n.m., se analizaron variables agronómicas; altura de planta, número y longitud de ramas, producción de materia seca total ha-1, y variables de calidad del forraje, digestibilidad de materia seca, proteína cruda, extracto etéreo, fibra detergente ácido, fibra detergente neutra, calcio, así como el contenido de taninos condensados de la leguminosa Lotus corniculatus, mediante un diseño completo al azar de cuatro tratamientos aplicados al suelo Tl: sin fertilizante; T2: biofertilizante; T3: fertilización química, y T4: biofertilizante más fertilización química, con tres repeticiones por tratamiento. Se utilizó análisis de varianza (ANOVA) y prueba de comparación de medias de Tukey al 0,1%. Los resultados señalan que el cultivo de L corniculatus, responde muy bien a la biofertilización, ya que el T2 exhibió el mejor comportamiento para la mayoría de variables agronómicas y de calidad del forraje, mientras que T4 mostró los mejores resultados para número de ramas y menos contenido de taninos condensados. En digestibilidad de la materia seca T2 y T4 ostentaron un buen comportamiento con diferencias altamente significativas con respecto a TI y T3; en contenidos de grasa y calcio, el mejor comportamiento se presentó en el T3 y TI con diferencias altamente significativas. Se concluye que la biofertilización incide de manera favorable en las características edáficas, producción y calidad del forraje Lotus corniculatus, con mejores comportamientos en las principales variables evaluadas en el estudio.
PALABRAS CLAVE: Variables agronómicas, calidad del forraje, digestibilidad de la materia seca, proteína cruda, fibra setergente neutra, fibra fetergente ácida, taninos condensados.
ABSTRACT: In the savannah of Bogotá, 2600 m.s.n.m., were analyzed Agronomic variables; plant height, number and length of branches, total dry matter yield ha-1, and quality variables of forage, dry matter digestibility, raw protein, ethereal extract, Fiber Acid Detergent, Neutral Detergent Fiber calcium, as well as the condensed tannin content of the legume Lotus corniculatus, by means of a complete random design of four treatments applied to the soil Tl: no fertilizer; T2: biofertilizer; T3: chemical fertilization, and T4: biofertilizer with chemical fertilization, with three replicates per treatment. It was used analysis of variance (ANOVA) and comparison test ofTukey averages at 0.1%. The results indicate that the cultivation of L corniculatus responds very well to biofertilization because T2 exhibited the best performance for most changeful agronomic and forage quality while T4 showed the best results for number of branches and less content of condensed tannins. In dry matter digestibility T2 and T4 showed good behavior with highly significant differences with respect to Tl and T3; In fat and calcium contents, the best behavior was presented in T3 and Tl with highly significant differences. It is concluded that biofertilization favorably influences the edaphic characteristics, production and quality of the forage Lotus corniculatus, with better behaviors in the main variables evaluated in the study
KEYWORDS: Agronomic variable, forage quality, Dry matter digestibility crude protein, Neutral Detergent Fiber Acid Detergent Fiber condensed tannins.
RESUMO: Na planície de Bogotá, 2600 m.s.n.m., variáveis agronômicas analisadas; altura das plantas, número e comprimento das ramificações, a produção de matéria seca total ha-1, e digestibilidade qualidade da forragem variável de matéria seca, proteína bruta, extrato etéreo, fibra em detergente ácido, neutro fibra em detergente, de cálcio, e o taninos condensados conteúdo Lotus corniculatus leguminosa de, utilizando um desenho de blocos completos ao acaso, quatro tratamentos aplicados ao solo T1: não fertilizados; T2: biofertilizante; T3: adubação química, e T4: biofertilizantes fertilização mais química, com três réplicas por tratamento. análise de variância (ANOVA) e teste de Tukey comparação foi utilizada a 0,1%. Os resultados indicam que a cultura de L. corniculatus, responde muito bem ao Biofertilização como o T2 exibiu o melhor desempenho para a maioria das características agronômicas e qualidade da forragem, enquanto T4 apresentaram os melhores resultados para número de agências emenor teor de taninos condensados. Na seca T2 de digestibilidade e T4 que ostentava um bom desempenho com diferenças altamente significativas em relação ao T1 e T3; em gordura e teor de cálcio, o melhor desempenho foi apresentado nas diferenças altamente significativas T3 e T1. Conclui-se que Biofertilização favoravelmente impactos sobre as características do solo, produção e qualidade de forragem Lotus corniculatus, com melhores performances nas principais variáveis avaliadas no estudo.
PALAVRAS-CHAVE: Variáveis agronómicas, a qualidade da forragem, de digestibilidade da matéria seca, proteína bruta, fibra detergente Neutra, fibra em detergente ácido, taninos condensados.
Introducción
Los sistemas de producción bovinos de leche especializados, ubicados en trópico alto en Colombia, aportan un poco más del 50% de la leche producida aunque solo poseen alrededor del 11.6% de la población bovina bajo ordeño (Osorio 2004, citado por Correa 2011). No obstante, la rentabilidad de esta actividad productiva ha disminuido de manera significativa en los últimos años, (Holmann et al., 2003, Correa 2011), y enfrenta una serie de amenazas que ponen en riesgo su competitividad, como consecuencia de procesos de globalización, alto grado de competencia al que están expuestos y problemáticas relacionadas con la oferta forrajera.
Estos sistemas productivos, se desarrollan en su mayor parte, con animales de alto valor genético, alimentos balanceados y forrajes propios de contextos agroecológicos en los que predominan las especies gramíneas como el kikuyo (Pennisetum clandestinum), el ryegrass (Lolium perenne) y el azul orchoro (Dactylis glomerata) (Correa, 2011). En la familia de las leguminosas, las especies forrajeras más utilizadas han sido la alfalfa (Medicago sativa), el trébol blanco (Trifolium pratense) y el trébol rojo (Trifolium pratense).
Lo expuesto muestra que la variedad de especies forrajeras de trópico alto es limitada y en gran parte, altamente dependiente de insumos agrícolas, en especial fertilizantes nitrogenados que restringen su productividad, por lo cual es importante investigar especies que garanticen disponibilidad de biomasa forrajera, de alto valor nutricional, como la leguminosa Lotus corniculatus, que además, presenta contenido taninos condensados, cuyos efectos pueden ser benéficos en el metabolismo de las proteínas en rumiantes. Al respecto, Cárdenas (2011), expone que esta leguminosa, constituye una alternativa alimenticia económica y sostenible para bovinos ubicados en ecosistemas de clima frío.
En coherencia con lo expresado, se adelantó el presente trabajo, el cual tuvo como principal objetivo determinar el efecto del biofertilizante y la fertilización química en variables agronómicas, calidad del forraje y contenido de taninos condensados en la leguminosa Lotus corniculatus en condiciones agroecológicas de trópico alto andino colombiano.
El trabajo fue desarrollado en una finca ubicada en la sabana de Bogotá, departamento de Cundinamarca Colombia (Latitud Norte: 4° 35>56>> y Longitud Oeste de Grennwich: 74°04>51>>) a 2600 m.s.n.m., con un diseño completo al azar, en el que se evaluó la producción de forraje, la calidad del mismo y la concentración de taninos condensados. Con la adecuación de parcelas de 3m x 2m, para cuatro tratamientos con tres repeticiones: TI: tratamiento control, T2: biofertilizante, T3: fertilización química y T4: biofertilizan-te + fertilización química, se dio inicio al ensayo, tomando muestras de suelo para identificar las condiciones edáficas iniciales.
Una vez modificadas las condiciones del suelo de acuerdo con cada tratamiento, y de realizar la siembra por material vegetativo, se llevó a cabo la medición de variables agronómicas, calidad del forraje y contenido de taninos con-densados, identificando diferencias estadísticas entre tratamientos, utilizando elementos de la estadística descriptiva e inferencial (Análisis de varianza -ANAVA y prueba de comparación múltiple de medias de Tukey).
Se pudo constatar que la especie Lotus corniculatus, responde favorablemente, a suelos con microrganismos como Trichoderma harziamum, Trichoderma viride Micorrizas (glomus, entrophosfora, entrophosfora, gigaspora, tecas-phora), Actinomycetos, mucorales, Rhizopus, Streptomyces y Aspergillus, tanto en variables agronómicas, como en calidad de forraje y contenido de taninos condensados.
1. Marco teórico
Las especies forrajeras tienen excelente capacidad para producir biomasa, la cual es una fuente económica para alimentar bovinos (Posada, 2005). Al respecto, en Colombia existe alta producción de forraje, en la que el componente leguminosa es de gran relevancia y constituye excelente alternativa para producir carne y leche a un costo razonable (Lascano, 1996). Según Carulla (2004), en trópico alto las gramíneas pueden encontrarse mezcladas con leguminosas como el trébol blanco (Trifolim pratense), el trébol rojo (T. repenss y la alfalfa (Medicago sativa), aunque recientemente se vienen estudiando otras especies que pueden aumentar la oferta de especies para la lechería como el Lotus spp, y la Festuca arundinacea. Según este autor, estas especies son de especial interés por su tolerancia al chinche (Colaria spp) y por presentar calidad nutricional aceptable. Así mismo, en la evaluación de especies no convencionales, con potencial forrajero asociado a estratos múltiples y a la sostenibilidad de las pasturas, se destacan los géneros Sambucus, Hibiscus, Morus y Alnus, debido a su aceptabilidad relativa por los bovinos.
Arboleda (2013), reporta que los géneros promisorios de trópico alto son: Dactylis, Lolium y Pennisetum debido a sus valores de proteína cruda (PC) superiores a 20 % y por su mayor digestibilidad in vitro (DIVMS), Lolium, Festuca y Phleum (>70%). Por otro lado, se reportan dentro de las leguminosas por su calidad nutricional y aceptabilidad por los bovinos géneros como Lotus, Medicago y Trifolium con PC mayor a 25% y DIVMS mayor de 70% (Jaimes 2002). Para Cárdenas (2011), el Lotus corniculatus o trébol pata de pájaro, constituye una alternativa alimenticia económica y sostenible para bovinos ubicados en ecosistemas de clima frío en Colombia y según Sosa (2008), resulta fundamental la introducción de leguminosas forrajeras, que muestren potencial productivo, facilidad de establecimiento, adaptación y adecuada persistencia. Guerrero et al. (2009), han encontrado que las vacas de leche que consumen leguminosas como el Lotus en asociación con kikuyo han incrementado el volumen de leche y el contenido de proteína láctea. Jajaja
L. corniculatus se adapta a suelos con intervalos de pH de 5.5 a 7.5 (Canals et al., 2009) y a condiciones de baja fertilidad en las que no podrían progresar otras leguminosas de trópico alto, como los tréboles (Grant, 2009). También tolera suelos con mal drenaje, debido a su sistema de raíz pivotante, profundo y ramificado (Cárdenas, 2011). Ramírez-Restrepo, (2006), expresa que las especies del género Lotus tienen ventajas en cuanto a su adaptación a condiciones adversas, como el exceso de agua en el suelo durante el invierno y malas condiciones de drenaje. En el mismo sentido, Artola (2004), afirma que este cultivo puede crecer en suelos pesados con excesos de humedad, adversos para Santacoloma-Varón et al.
Entramado Evaluación de variables agronómicas, calidad del forraje y contenido de taninos condensados de la leguminosa Lotus corniculatus en respuesta a biofertilizante y fertilización química en condiciones agroecológicas de trópico alto andino colombiano cultivos como la alfalfa o demasiado secos como para el trébol blanco. Así mismo, Striker, (2005), expone que el L. corniculatus, se adapta a la salinidad, acidez, baja fertilidad y tierras agotadas a lo que Scott &Charlton, (1982), afirman que estas especies, crecen bien en suelos de baja fertilidad, con problemas de disponibilidad de P y K especialmente, sin requerir de altas aplicaciones de éstos y otros elementos.
Por su parte, L. corniculatus presenta excelente calidad nutricional, con niveles de proteína entre 17,7 y 21.6% (Marley et al., 2006), con menos contenido de celulosa y mayor contenido de carbohidratos no estructurales (Grant, 2009). La presencia de taninos en esta especie es una de las cualidades que se destaca, toda vez que a nivel ruminal no produce timpanismo, gracias a que estos metabolitos impiden la formación de gases y espuma (Lagler, 2003; citado por García 2011).
El comportamiento agronómico nutricional y el metabolismo secundario del L. corniculatus, varía sensiblemente frente a prácticas de manejo y condiciones ambientales. En este sentido Barahona et al. (2003), expresan que la fertilidad del suelo induce a cambios en la composición química del forraje. Así las cosas, Santacoloma et al. (2015), hallaron que el contenido de proteína, la FDA y FDN varió de manera significativa en suelos de alta fertilidad respecto a suelos a los cuales se les adicionó arena, el incremento de los contenidos de arena en el suelo, afectó de manera negativa el tenor proteico del forraje reflejando reducido aporte de nutrientes por parte del suelo.
Así mismo, se ha identificado alta incidencia en la concentración de taninos con respecto a la mayor fertilidad del suelo. Al respecto, Barry & Mc Nabb (1989), citado por Berard (2011) reportan concentración de taninos condensa-dos de 8 a 11% en L. pedunculatus en suelos ácidos, sin aplicaciones de fertilizantes, mientras que en condiciones de mejor calidad mostraron valores tan solo de 2 a 3%. Al respecto, Waterman & Mole (1995), reportan que el tipo y el contenido de taninos, están influenciados por el genotipo de la planta (la especie y la variedad), las características ambientales (radiación solar y disponibilidad de agua), la velocidad de crecimiento, la madurez, la condición nutricional del suelo, la depredación y las enfermedades.
Por lo expuesto, resulta necesario investigar en esta leguminosa su interacción con el ambiente, particularmente con el factor suelo, el cual es uno de los componentes con alta incidencia en la producción de forraje, en su calidad nutricional y en el contenido de metabolitos secundarios (Santacoloma & Granados, 2012). En este sentido, la pregunta central de la investigación es: ¿Cuál será la respuesta agronómica, calidad del forraje y contenido de taninos condensados de la leguminosa Lotus corniculatus a la biofertilización, y a la fertilización química en condiciones de trópico alto?
2. Materiales y Métodos
2.1. Localización
El trabajo se llevó a cabo en un finca ubicada en la sabana de Bogotá, departamento de Cundinamarca-Colombia (Latitud Norte: 4° 35>56>> y Longitud Oeste de Grennwich: 74°04>5I>>) a 2600 m.s.n.m., dentro de la zona de confluencia intertropical, la cual tiene comportamiento bimodal de lluvias; en la primera mitad del año, durante los meses de marzo, abril y mayo y en la segunda, en los meses de septiembre, octubre y noviembre, precipitación que oscila entre 745 y 1941 mm/año, temperatura media de 14 °C. y humedad relativa de 80% (Díaz Granados, 2005).
2.2. Adecuación de parcelas y fertilización
En un diseño completo al azar, se evaluó la producción de forraje, la calidad del mismo y la concentración de taninos condensados, para lo que se adecuaron parcelas de 3m x 2m, para cuatro tratamientos con tres repeticiones:
TI: tratamiento control,
T2: biofertilizante,
T3: fertilización química y
T4: biofertilizante + fertilización química.
Al tratamiento 2, se le aplicó modificaciones en sus condiciones físicas, químicas y microbiológicas, mediante la incorporación de un biofertilizante a razón de 1200 kg ha-1, el cual contenía microrganismos como Trichoderma harziamum, Trichoderma viride, Micorrizas (glomus, entrophosfora, entrophosfora, gigaspora, tecasphora,) Actinomycetos, mucorales, Rhizopus, Streptomyces y Aspergillus. (Ver Figura 1, 2 y 3).

El tratamiento 3, consistió en la aplicación de un fertilizante químico, formulado de acuerdo con las necesidades del cultivo: Nitrógeno en dosis de 50 kg ha-1 (fuentes: Sulfato de amonio 21%), 30 kg P ha-1 antes de la siembra al fondo del surco, 40 kg de Mg ha-1 (sulfato de magnesio 10%), 50% en presiembra y 50% cuando la planta tuvo raíces verdaderas.
Por su parte, el tratamiento 4, recibió tanto el biofertilizante como la fertilización química (Ver Figura 1, 2 y 3).

2.3. Muéstreos y condiciones edificas iniciales
Al iniciar y finalizar el ensayo se tomaron muestras de suelo, utilizando el método de zig-zag para cuantificar en ellas variables de fertilidad y evaluar su efecto en el cultivo.
Las características físicas del suelo original evidenciaron textura Franco Arcillo Arenosa (FArA) predominante, es decir moderadamente fino, lo cual le confiere moderada capacidad de circulación de agua, aire, infiltración y mediana retención de humedad; densidad aparente (g/cc) de 1,39 Mg m-3, permite entrever que el cultivo podría presentar riesgo medio en el enraizamiento y en la elongación y penetración de las raíces para alcanzar el agua y los nutrientes necesarios para el normal crecimiento de la planta.
El pH elevado (7.5), supone la presencia de alto contenido de carbonatos que podrían reaccionar con los micronutrientes originando carbonatos insolubles, elevada saturación de bases y baja disponibilidad de P. Por su parte los elevados contenidos de K (0,79 cmol(+) kg-1) y Ca (10.30 cmol(+) kg-1), sugieren posible deficiencia inducida de Mg y a la vez, la probable reacción con el P para formar fosfatos de calcio insoluble a este pH.
2.4. Medición de variables agronómicas y de calidad de forraje
Para determinar la altura de la planta fueron seleccionadas de manera aleatoria 15 plantas por parcela, las cuales se midieron utilizando cinta métrica, tomando desde la base del suelo hasta su parte más alta, durante dos momentos del ensayo, a 90 y 150 días de edad. Para establecer el número de ramas, se seleccionaron al azar 15 plantas por parcela y se procedió a contar su número, en dos momentos de la investigación, a los 90 y 150 días. En el cálculo de producción de forraje (kg MS ha-1) se realizó un aforo de cada parcela, a los 150 días de edad y el material vegetal fue lavado con agua destilada desionizada, secado al sol, pesado y empacado en papel Kraft para posteriormente llevarlo a un horno por 24 horas a 60°C hasta obtener masa constante; el valor fue extrapolado para cuantificar la producción de materia seca de forraje por hectárea año-1.
La determinación de proteína cruda, se realizó con el procedimiento reportado en Licitra (1996) y los de fibra detergente neutro (FDN) y fibra detergente ácido (FDA), siguiendo la metodología de Richter (1991). Todos los análisis fueron realizados en el Laboratorio de Servicios Analíticos del Centro Internacional de Agricultura Tropical (CIAT -Palmira).
Para la determinación de taninos condensados, muestras de cada tratamiento fueron empacadas en bolsas negras, rotuladas adecuadamente, para ser transportadas hasta el laboratorio y sometidas a proceso de secado al horno, a 105°C durante 6 horas para posterior tamizaje fitoquímico y determinación de estos fitometabólitos por el método descrito por Terril et al., 1992. La Tabla 1 resume las técnicas empleadas para determinar la calidad del forraje.

2.5. Diseño experimental.
Para determinar el efecto de la fertilidad del suelo sobre las variables estudiadas, se empleó un diseño completamente al azar, con cuatro tratamientos y tres repeticiones por tratamiento, siendo la unidad experimental una parcela de 3m*2m.
El modelo estadístico utilizado fue:

Donde:
Yij = Variable respuesta en la j-ésima repetición del i-ésimo tratamiento
μ = Media general
τi = Efecto del tratamiento i. (TI: parcela testigo en la cual no se realizó ningún proceso de fertilización, T2: aplicación de biofertilizante, T3 aplicación de fertilizante químico y T4 aplicación de biofertilizante y fertilizante químico
Eij =Error aleatorio


2.6. Análisis estadístico
Las diferencias estadísticas entre tratamientos se evaluaron utilizando elementos de la estadística descriptiva (Media, desviación estándar, coeficiente de variación y límites de confianza de la media) e inferencial (Análisis de varianza -ANAVA y prueba de comparación múltiple de medias de Tukey). Para los datos que no cumplieron supuestos de normalidad, se recurririó al empleo de la prueba de Kruskal-Wallis como método no paramétrico para el análisis de varianza. Los datos obtenidos fueron analizados con los software estadísticos R ( R Core Team, 2015), SPSS y Microsoft Excel.
3. Resultados y discusión
3.1. Análisis de suelo
Los resultados obtenidos en el análisis de suelos posterior al acondicionamiento se muestran en la Tabla 2 y en la Figura 6.


Se aprecia que las condiciones de pH son similares en los cuatro tratamientos (pH entre 7 y 7.5) con tendencia a la alcalinidad pero aceptable desde el punto de vista agrícola; textura franco arcillo arenosa, contenido de materia orgánica promedio para las condiciones climáticas, capacidad de intercambio catiónico media, siendo los tratamientos 2, 3 y 4, los que exhibieron con diferencias estadísticas, los más altos promedios en esta variable con 13.17, 13.47 y 13.53 cmol(+)kg-1, respectivamente. Los contenidos de K+ y Ca+2, son elevados que, junto a los bajos contenidos de Mg (<1.5cmol(+)kg-1), se puede configurar deficiencia inducida de este último elemento como resultado del exceso de los otros iones. Los cuatro tratamientos presentan alto contenido de fósforo disponible, siendo superior en el T4 (575.67 mg kg-l) seguido del T3 con 477.67 mg kg-1.
3.2. Análisis de la producción de forraje
Entre las variables de producción de forrajes analizadas, el número de ramas, a los tres y cinco meses, el tratamiento 4, obtuvo un mejor comportamiento con 13.71, seguido del tratamiento 2 con 12.2, con diferencias estadísticas (P<0,05) con respecto a los tratamientos 1 y 3 (9.36 y 10.76, respectivamente). Lo anterior se puede explicar por las mejores condiciones del suelo que se expresan en los indicadores de fertilidad, lo que es coherente con lo expuesto por Canals et al., (2009), cuando expresa que la especie L. corniculatus, se adapta a suelos con intervalos de pH de 5,5 a 7,5 y con Grant (2009), quien plantea que esta especie se acomoda a condiciones en las cuales otras leguminosas no podrían progresar.
La variable longitud de las ramas, evaluada a los tres y cinco meses, obtuvo el mejor comportamiento en el T2 (biofertilizante) con 33.22 cm, seguido del T4 (biofertilizante + fertilización química) con 28.1 cm, diferenciándose (P<0,05) de TI (Control) y T3 (abono químico) (18.96 y 19.21 cm, respectivamente). Estos resultados muestran una respuesta positiva del forraje a la aplicación de abonos biológico como Trichoderma harziamum, y Trichoderma viride que según Stefanova (2000), producen sustancias promotoras de crecimiento de las plantas. En el mismo sentido, Tobar (2008) expone que se ha encontrado en la especie Trichoderma harzianum, un potencial para incrementar el desarrollo de las plantas, probablemente por el control de patógenos menores y producción de factores que favorecen la nutrición vegetal. (Ver Figura 7).

En la producción de biomasa, calculada a partir de la realización de un aforo (lm2) de cada parcela, se obtuvo mejor comportamiento en el T2 y T4 (108.53 y 10.916,67 kg ha-1. año), los que se diferenciaron (P<0,05) del TI (5820 kg ha-1. año) y T3 (5.626,67 kg ha-1. año). Estos resultados coinciden con lo expuesto por Benítez et al. (2004), en el sentido de que la aplicación de biofertilizantes con Trichoderma, incrementa el rendimiento de las raíces de las plantas y la productividad del cultivo, disminuye el estrés abiótico y mejora la toma y uso de nutrientes por la planta. Así mismo, Pastor et al. (2015), demostraron que la aplicación de diferentes concentraciones de inóculo de T. harzianum, produjo un notable incremento en la cosecha de un cultivo como el maní.
Po su parte, tanto Barea et al. (2004) y Artursson et al. (2006), encontraron que la presencia de hongos formado-res de Micorriza tiene efecto sobre el crecimiento de las plantas, como resultado de la adquisición de nutrientes e inhibición de crecimiento de hongos patógenos y por mejora en la ramificación del sistema de raíces (Gamalero et al., 2004).
Respecto a la producción de masa seca por unidad de área, el mejor comportamiento fue reportado por T2 (7.078 kg ha-l) seguido de T4 (7.021,33 kg ha-l), los cuales en promedio superaron en 57% a T1 y T3. Los tratamientos mostraron producciones entre 3.600 y 7.125 kg ha-1 año, datos inferiores a los reportados por Zarza (2007), quien registró producciones de 9.200 a 10.380 kg MS ha-1 año en un experimento con dos cortes en el primer año de establecimiento de L. corniculatus. No obstante, los datos obtenidos coinciden con Marley (2006) & Pecetti et al. (2009) quienes reportan producciones entre 6.000 y 4.470 kg de MS ha-1 año, respectivamente. La respuesta del cultivo de L. corniculatus a la aplicación de biofertilizantes como Trichoderma, es coherente con lo expresado por Tobar (2008), al exponer que en plantas de fríjol, este organismo estimuló la germinación y la altura de la planta, entre 70 y 80%.
3.3. Análisis de calidad del forraje
Con respecto a la calidad del forraje, el tratamiento 2 presentó el mejor comportamiento en contenido de materia seca y digestibilidad. Este último parámetro mostró con diferencias (P<0,05) que T2 y T4 (72%) superaron a T1 y T3 (67.33 y 70.3%, respectivamente). Lo anterior, señala que las características ambientales, como son las condiciones edáficas, influyen sobre la producción de materia seca de los forrajes y por tanto, sobre el establecimiento de especies de clima templado en condiciones tropicales de altura.
Así mismo, en FDN se presentaron diferencias (P<0,05) entre tratamientos, con mejor comportamiento del T2 (45%), diferenciándose del T3 (51.33%), resaltando que concentraciones elevadas en FDN en los forrajes no son aconsejables para asegurar la calidad en el mismo. Con respecto al FDA, se observaron diferencias (P<0,05) entre tratamientos, siendo T4 y T2 los que mostraron mejor comportamiento estadístico por su menor concentración (23.33 y 24%, respectivamente), mientras el T3, presentó la mayor concentración de este componente (25.67%).
Estos resultados permiten deducir que la fertilidad del suelo influye en el contenido de FDN y FDA, mostrando que a medida que se incrementa la fertilidad del recurso, los tenores en FDN y FDA disminuyen.
3.4. Contenido de proteína
Se encontraron diferencias (P<0,05), siendo el T2 el que mostró el mejor comportamiento estadístico (248 g kg-1), superando en 22% a T1 que presentó el promedio más bajo (194.33 g kg-1). Los datos muestran claramente que mejores condiciones de suelo, afectan de manera positiva el tenor proteico del forraje, lo que coincide con lo reportado por Marley et al. (2006), quienes obtuvieron contenidos de proteína en sus estudios en rangos entre 17,7 y 21,6 % en cultivo de Lotus corniculatus.
El contenido de grasa (EE), que según Van Soest, (1994), en las hojas de forrajes está compuesto por galactolípidos y fosfolípidos, mostró diferencias (P<0,05) entre tratamientos, siendo el T3 el de mejor comportamiento (105.33 g kg-1), mientras el tratamiento 1, presentó el comportamiento más bajo, con menor concentración de EE en el forraje (71 g kg-1).
Respecto al contenido de calcio, T3 presentó (P<0,05) la menor concentración en el elemento (24,63 g kg-l), mientras T2 obtuvo los mayores promedios en la variable (29.33 g kg-1).

3.5. Taninos condensados
Se encontró diferencia significativa (P<0,05), entre tratamientos. De la Figura 9 se destaca que los tratamientos donde se incluyó fertilizante químico y biológico mostraron menor contenido de taninos condensados en las plantas. El T4 mostró el mejor comportamiento estadístico (3.04%), por su menor concentración en la MS, mientras el Tl, presentó el promedio más alto (7.15%). Lo anterior coincide con Waghorn, et al. (2003), quienes expresan que las concentraciones de taninos condensados en hojas de Lotus corniculatus, aumentaron cuando las condiciones del suelo fueron pobres. En este mismo sentido, Barry et al. (1999), encontraron que la concentración de taninos condensados en L.pedunculatus fue de 11.8% de la MS, cuando se cultivó en suelos ácidos, sin aplicación de fertilizantes y de 2.3% de MS cuando se cultivó en suelos con alta fertilidad.
Lo anterior podría explicarse porque la concentración de iones en la solución del suelo, junto con las propiedades físico-químicas del mismo, pueden afectar la movilización de nutrientes desde el suelo a la planta (Jungk 2001). Otros factores ambientales también afectan el contenido de taninos condensados. Al respecto, Robbins (2005), encontró que los niveles de taninos se incrementaron en hojas y tallos de L. corniculatus al duplicarse el CO2, dado que los taninos condensados tienen la capacidad para adherirse a otras moléculas, como proteínas, polisacáridos, minerales, carbohidratos, celulosa, células de las membranas bacterianas y enzimas involucradas en la digestión de los compuestos antes mencionados, la unión con proteínas es una de las características que presentan mayor impacto en la nutrición animal. Lo anterior, lo enfatizan Lara & Londoño (2008) al exponer que cantidades moderadas de taninos condensa-dos producen efectos benéficos sobre el metabolismo de las proteínas en rumiantes, debido a que reducen la degradación de la dieta proteínica en el rumen e incrementan la absorción de aminoácidos en el intestino delgado.
Conclusiones
Los resultados obtenidos en la presente investigación permiten concluir que el crecimiento y la producción de biomasa del cultivo corniculatus, responde a cambios en las condiciones biológicas, químicas y físicas del suelo. Al respecto, se logró establecer que al suelo al cual se le incorporaron microrganismos como Tri-choderma harziamum, Trichoderma viride Micorrizas (glomus, entrophosfora, entrophosfora, gigaspora, te-casphorá), Actinomycetos, mucorales, Rhizopus, Streptomycesy Aspergillus se obtuvieron incrementos en las variables agronómicas evaluadas.

Las características de fertilidad del suelo, propiciada por la adición de microorganismos, inciden de manera significativa en la calidad del forraje de Lotus corniculatus, lo que se refleja en digestibilidad de la materia seca, contenido de proteína, calcio, fósforo, lípidos y que se obtuvo en los suelos con mejores condiciones fisicoquímicas y microbiológicas. El bajo contenido de FDN y FDA, en forraje de L. corniculatus en el suelo con mejores condiciones de fertilidad, también es una expresión de la relación entre la fertilidad del suelo y la calidad del forraje.
En suelos de más alta fertilidad se presenta una disminución del contenido de metabolitos en el forraje estudiado, lo cual muestra las relaciones entre el suelo y el metabolismo secundario de las plantas (taninos condensados) y constituyen un factor importante para disminuir el efecto adverso que tienen algunos forrajes sobre la digestión y absorción de nutrientes en rumiantes.
Referencias bibliográficas
1. ARBOLEDA, Denis; et al . Propuesta para el establecimiento de especies arbóreas y arbustivas con potencial forrajero en sistemas de producción ganadera del trópico alto colombiano. En: Biotecnología en el Sector Agropecuario y Agroindustrial. 2013. vol. 11, no 1, p. 154-163.
2. ARTOLA, Alberto. Lotus corniculatus-Morfología, desarrrollo y producción de semillas.[Morphology, development and production of seeds]. En: Ciencia. 2004. Disponible en: Disponible en: http://www.ciencia.net/VerArticulo/Lotus-corniculatus-Morfología,-Desarrollo - y -ProduccióndeSemillas?idArticulo=5130 (consultado 18 de julio de 2015).
3. ARTURSSON, Veronica; FINLAY, Roger and JANSSON Janet K. Interactions between arbuscular mycorrhizal fungi and bacteria and their potential for stimulating plant growth. In: Environmental microbiology, 2006. vol. 8, no 1, p. 1-10.
4. BARAHONA, Rolando, et al . In vitro degradability of mature and immature leaves of tropical forage legumes differing in condensed tannin and no-starch polysaccharide content and composition. in: Journal of the Science of Food and Agriculture. 2003. vol. 83, no 12, p. 1256-1266.
5. BAREA, José-Miguel, et al. Microbial co-operation in the rhizosphere. in: Journal of experimental botany. 2005. vol. 56, no 417, p. 1761-1778.
6. BARRY, Tim.; MCNABB, William. The implications of condensed tannins on the nutritive value of temperate forages fed to ruminants. in: British Journal of Nutrition. 1999. vol. 81, no 04, p. 263-272.
7. BENITEZ, Tahía, et al Mecanismos de biocontrol de cepas de Trichoderma. En: International Microbiology. 2004. vol. 7, no 4, p. 249-260.
8. BERARD, Nick. C., et al Condensed tannin concentrations found in vegetative and mature forage legumes grown in western Canada. In: Canadian Journal of Plant Science. 2011. vol. 91, no 4, p. 669-675.
9. CANALS, Rosa María; PERALTA, Javier y ZUBIRI, Eduardo. Vicia sativa L.: veza. Departamento de Producción Agraria, Herbario UPNA-Departamento de Ciencias del Medio Natural. España: Universidad Pública de Navarra. 2009. http://www.unavarra.es/herbario/pratenses/htm/Vici_sati_p.htm
10. CARDENAS ROCHA, Edgar. Lotus; nueva leguminosa forrajera para los sistemas lecheros de clima frío y zonas templadas. Bogotá: Universidad Nacional de Colombia, Editorial Produmedios. 2011.
11. CARULLA Juan E., et al Valor nutricional de los forrajes más usados en los sistemas de producción lechera especializada de la zona andina colombiana. Seminario Nacional de Lechería Especializada: "Bases Nutricionales y su Impacto en la Productividad". Medellín, septiembre, 2004.vol. 1, p. 21-38.
12. CORREA CARDONA, Héctor J. Efecto del manejo del pastoreo y la suplementación alimenticia en vacas lactantes de sistemas especializados sobre su metabolismo energético y proteico y el contenido de proteína en la leche. Tesis de grado para optar el título de Doctor. Bogotá: Universidad Nacional de Colombia. 2011.
13. DIAZ-GRANADOS, Mario; NAVARRETE, Juan y SUAREZ Tatiana. Páramos: Hidrosistemas Sensibles En: Revista de Ingeniería Facultad de Ingeniería Universidad de los Andes. July/Dec 2005. vol 22 p. 64-75.
14. GAMALERO, Elisa, et al Impact of two fluorescent pseudomonads and an arbuscular mycorrhizal fungus on tomato plant growth, root architecture and P acquisition. In: Mycorrhiza. 2004. vol. 14, no 3, p. 185-192.
15. GARCÍA, Marina; GARCÍA, Grisaly y SANABRIA María Elena. Efecto de la salinidad sobre el crecimiento, daño oxidativo y concentración foliar de metabolitos secundarios en dos variedades de caraota (Phaseolus vulgaris L.). En: Interciencia. 2010. vol. 35, no 11, p. 840-846.
16. GARCIA, Dany., et al Variabilidad fitoquímica y repercusión antinutricional potencial en especies del género Albizia. Pastos y Forrajes. 2007. vol. 30, no 1, p. 1-1.
17. GRANT, William. Lotus corniculatus . En: SciTopics. 2009. Disponible en Disponible en http://www.scitopics.com/Lotus_corniculatus.html (accesado el 20 de enero de 2015).
18. HOLMANN, Federico; et al . Evolution of Milk Production Systems in Tropical Latin America and its interrelationship with Markets: An Analysis of the Colombian Case. In: Livestock Research for Rural Development. 2003. vol. 15, no. 9.
19. JAIME, Eduardo. Estudio exploratorio de la calidad nutricional de gramíneas, leguminosas y arbóreas de la Unidad de Recursos Genéticos de Forrajes (Universidad Nacional de Colombia-sede Bogotá). Trabajo de grado. Bogotá: Universidad Nacional de Colombia Facultad de Medicina Veterinaria y de Zootecnia. Departamento de Ciencias para la Producción Animal. 2002.
20. JUNGK, Albrecht. Root hairs and the acquisition of plant nutrients from soil. In: Journal of Plant Nutrition and Soil Science. 2001. vol. 164, no 2, p. 121-129.
21. LASCANO, Carlos Et al Oportunidades y retos en la utilización de leguminosas arbustivas como forraje suplementario en sistemas de doble propósito. Leguminosas forrajeras arbóreas en la agricultura tropical, 1996.
22. LICITRA, G.; HERNÁNDEZ, T. M.; VAN SOEST, P. J. Standardization of procedures for nitrogen fractionation of ruminant feeds. In: Animal Feed Science and Technology. 1996. vol. 57, no 4, p. 347-358.
23. MARLEY, Christina; FYCHAN, Richard y JONES, Raymond. Yield, persistency and chemical composition of Lotus species and varieties (birdsfoot trefoil and greater birdsfoot trefoil) when harvested for silage in the UK. In: Grass and Forage Science. 2006. vol. 61, no 2, p. 134-145.
24. MÁRQUEZ, Dildo y SUÁREZ, Álvaro. El uso de taninos condensados como alternativa nutricional y sanitaria en rumiantes. En: Revista Medicina Veterinaria. 2008. no 16, p. 87-109.
25. MIN, Barry., et al . The effect of condensed tannins from Lotus cor-niculatus on the proteolytic activities and growth of rumen bacteria. In: Animal Feed Science and Technology. 2005. vol. 121, no 1, p. 45-58.
26. PASTOR, N. A., et al . Bioproducto a base de Trichoderma controla el carbón de maní y aumenta de rendimiento del cultivo. En: Jornada Nacional de Maní. 30. 2015 09 17, 17 de septiembre 2015. General Cabrera, Córdoba. AR., 2015.
27. POSADA, José Oscar Sierra. Fundamentos para el establecimiento de pasturas y cultivos forrajeros. Universidad de Antioquia, 2005.
28. POSADA, Sandra; MONTOYA, Giovanny y CEBALLOS, Alejandro. Efecto de los taninos sobre la digestión, el metabolismo y la producción en rumiantes. En: Bioquímica, nutrición y alimentación de la vaca. Biogénesis. Medellín, Colombia, 2005.
29. RAMÍREZ-RESTREPO, Carlos, et al Production of Lotus corniculatus L. under grazing in a dryland farming environment. En: New Zealand Journal of Agricultural Research. 2006. vol. 49, no 1, p. 89-100.
30. RICHTER, Ronald. Journal of Dairy Science 1991. In: Journal of Dairy Science. 1992. vol. 75, no 3, p. 898-903.
31. SCHERER, Michelle; et al Chemistry and microbiology of permeable reactive barriers for in situ groundwater clean up. In: Critical Reviews in Microbiology. 2008.
32. ROBBINS, Mark P.; et al. A comparison of two strategies to modify the hydroxylation of condensed tannin polymers in Lotus corniculatusIn :Phytochemistry. 2005. vol. 66, no 9, p. 991-999.
33. SANTACOLOMA, Luz y GRANADOS, Jairo. Interrelación entre el contenido de metabolitos secundarios de las especies Gliricidia sepium y Tithonia diversifolia y algunas propiedades físicoquímicas del suelo. En: Revista de Investigación Agraria y Ambiental. 2012,. vol. 3, no 1, p. 53.
34. SANTACOLOMA, Luz; GRANADOS, Jairo y AGUIRRE, Sonia. Comportamiento agronómico, nutricional y contenido de taninos de la leguminosa Lotus corniculatus como efecto de la fertilidad del suelo. En: Revista Ciencia Animal. 2015. no 9, p. 189-208.
35. SOSA, Edgar, et al . Producción estacional de materia seca de gramíneas y leguminosas forrajeras con cortes en el estado de Quintana Roo. En: Revista Mexicana de Ciencias Pecuarias. 2012. vol. 46, no 4, p. 413-426.
36. SCOTT, D.; CHARLTON, J. F. L. Birdsfoot trefoil (Lotus corniculatus) as a potential dryland herbage legume in New Zealand. In: Proceedings of the New Zealand Grassland Association. 1982.
37. STRIKER, Gustavo. et al. Physiological and anatomical basis of differential tolerance to soil flooding of Lotus corniculatus L and Lotus glaber Mill . In: Plant and Soil. 2005. vol. 276, no 1-2, p. 301-311.
38. TEAM, R. Core, et al . R: A language and environment for statistical computing. 2013.
39. TERRILL, T. H., et al . Determination of extractable and bound condensed tannin concentrations in forage plants, protein concentrate meals and cereal grains. Journal of the Science of Food and Agriculture. 1992. vol. 58, no 3, p. 321-329.
40. TOVAR CASTAÑO, Julio César. Evaluación de la capacidad antagonista" in vivo" de aislamientos de trichoderma spp frente al hongo fitopatogeno rhizoctonia solani. 2008.
41. VÁSQUEZ MORENO, Luis y FERNÁNDEZ CONZÁLVEZ, Emilio. Manejo agroecológico de plagas y enfermedades en la agricultura urbana. Estudio de caso ciudad de La Habana, Cuba. En: Agroecología, 2008, vol. 2, p. 21-31.
42. VAN SOEST, Peter. J., et al. Use of detergents in analysis of fibrous feeds. 3. Study of effects of heating and drying on yield of fiber and lignin in forages. Journal of the Association of Official Agricultural Chemists. 1965. vol. 48, p. 785-790.
43. VAN SOEST, Peter J., Nutritional ecology of the ruminant. Ithaca: Cornell University Press, Cornell University, 1994. 476 p
44. MIN, B. R., et al . The effect of condensed tannins on the nutrition and health of ruminants fed fresh temperate forages: a review. In: Animal Feed Science and Technology. 2003. vol. 106, no 1, p. 3-19.
45. WATERMAN, P G.; MOLE, S.; TOMAS-BARBERAN, F. A. Analysis of phenolic plant metabolites. In: Phytochemistry. 1995. vol. 38, no 4, p. 1064.
46. ZARZA, Rodrigo; et al . Colecta y caracterización de poblaciones criollas de Lotus corniculatus en Uruguay. In: Lotus Newsletter. 2007.
Notas
Notas
Declaración de intereses